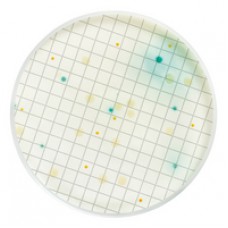
MEIO PSEUDOMONAS EM AMPOLA 2ml (CX) MILLIPORE
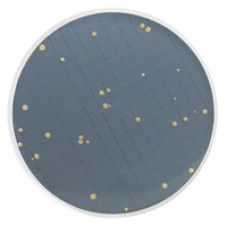
MEIO PRY EM AMPOLA 2ml PARA LEVEDURAS RESISTENTES A CONSERVANTES (CX) MILLIPORE
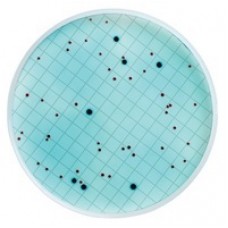
MEIO M FC EM AMPOLA 2ml PARA COLIFORMES FECAIS (CX) MILLIPORE
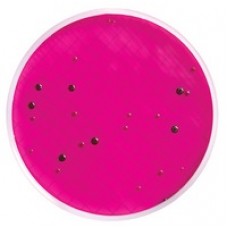
MEIO M ENDO EM AMPOLA 2ml PARA COLIFORMES TOTAIS (CX) MILLIPORE

MEIO PRY EM AMPOLA 2ml PARA LEVEDURAS RESISTENTES A CONSERVANTES (CX) MILLIPORE
Modelo: MHA00PRY2
R$1.090,90
MEIO M FC DESIDRATADO FRASCO COM 113,5g PARA DETERMINACAO DE COLIFORMES FECAIS (EMB) MILLIPORE
Modelo: MB000000F
R$1.114,29
MEIO DE CULTURA ESGRO COMPLETO MEIO BASAL TEMPERATURA TRANSPORTE E ARMAZENAMENTO -20C 100ML (UND) MILLIPORE
Modelo: SF002-100
R$6.449,69
MEIO DE CULTURA ENDOGRO SUPLEMENTO TEMPERATURA TRANSPARMAZ -20C (KIT) MILLIPORE
Modelo: SCME002-S